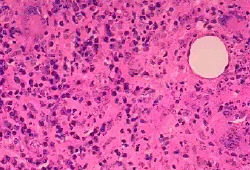
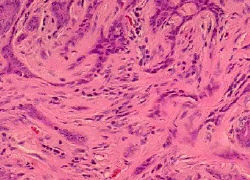

a. |
b. |
c. |
d. |
e. |
f. |
1. |
2. |
3. |
4. |
5. |
6. |
Match the eyelid skin lesions (in alphabets) with their histological appearance (in numbers)












a. |
b. |
c. |
d. |
e. |
f. |
1. |
2. |
3. |
4. |
5. |
6. |
Match the eyelid skin lesions (in alphabets) with their histological appearance (in numbers)

| More MCQs questions |